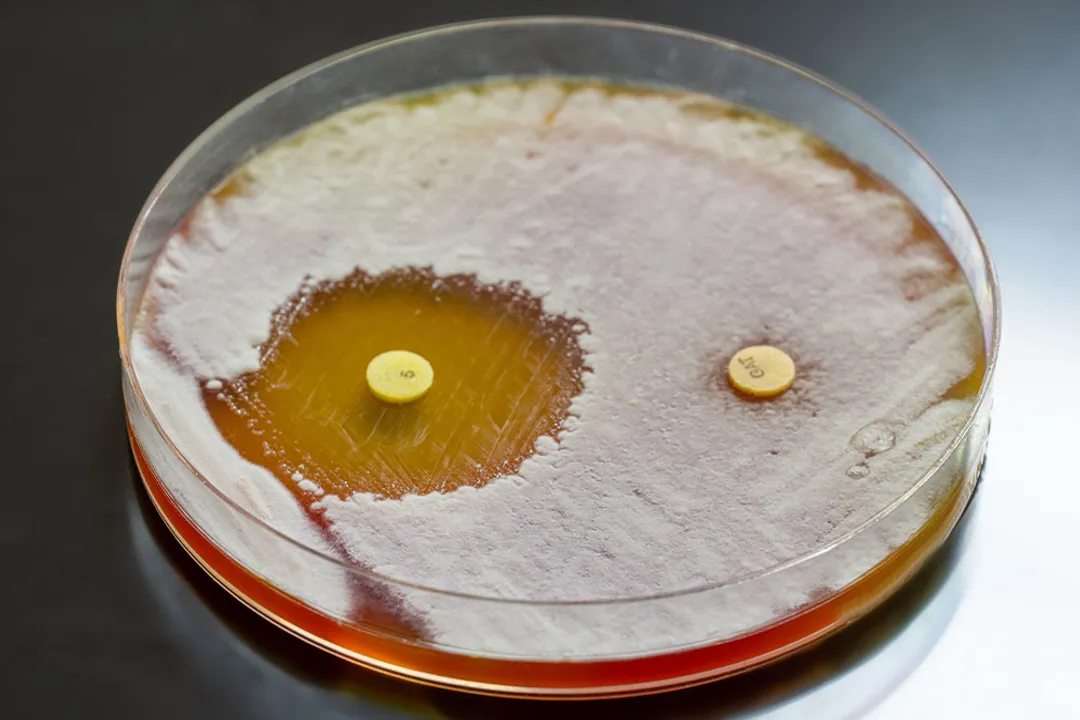
How do pathogens develop drug resistance?, Genetic Changes

How do pathogens develop drug resistance?

Antimicrobial resistance (AMR) is a quiet crisis where germs like bacteria, viruses, fungi, and parasites evolve to fight off the drugs designed to kill them. [2][6] When this happens, the drugs become ineffective, making infections harder to treat and increasing the risk of disease spread, severe illness, and death. [4][6] It is important to recognize that this phenomenon isn't limited to just bacteria developing resistance to antibiotics; resistance occurs across the entire spectrum of microbes treated with antimicrobials, including antivirals and antifungals. [2][6] The danger is that common infections, which were once easily managed, can become life-threatening again when the standard treatments fail. [1][4]
# Defining Resistance

Drug resistance occurs when a microorganism changes in a way that reduces or eliminates the effectiveness of a drug designed to inhibit or kill it. [7] This capability is an evolutionary trait that develops naturally over time, but human actions significantly speed up the process. [7][8] Pathogens are inherently adaptive; they possess genetic material that allows them to change their structure or function when exposed to environmental stress, like the presence of a therapeutic drug. [3]
For example, a bacterium might become resistant to a specific antibiotic through a spontaneous alteration in its DNA, or it might acquire a resistance gene from another bacterium that has already developed protection. [3][7] The clinical outcome is clear: if an infection is caused by a resistant strain, conventional treatment regimens no longer work, necessitating the use of alternative, sometimes less effective, or more toxic drugs, or even leading to treatment failure. [4] The problem affects the entire health system, making routine procedures like surgery or chemotherapy riskier because the backup plan against secondary infections is compromised. [1]
# Genetic Changes
The foundation of drug resistance lies within the microbe's genetic code, typically its DNA. [3] Pathogens develop resistance through two primary mechanisms involving their genes: random mutation and the exchange of genetic material with other microbes. [3][7]
# Spontaneous Alteration
Sometimes, during the normal process of copying their DNA when they reproduce, pathogens make small, random errors—these are mutations. [7] If one of these errors happens to occur in a gene that controls how the microbe interacts with an antimicrobial drug, that microbe might suddenly survive an exposure that would have killed its non-mutated neighbors. [3] This single bacterium, now resistant, has a survival advantage in an environment where the drug is present. [7]
# Gene Transfer
More concerning than spontaneous mutation is the ability of pathogens to share resistance genes directly with each other, a process known as horizontal gene transfer. [3][7] This is like a cheat code being passed from one organism to another, even between different species of bacteria. [3] Bacteria can share resistance through several methods, including:
- Conjugation: Bacteria connect via a tube-like structure called a pilus and transfer a small piece of DNA, often in the form of a plasmid, directly from one cell to another. [3]
- Transformation: A bacterium picks up free-floating DNA fragments released by dead, ruptured bacteria in its environment. [3]
- Transduction: A virus that infects bacteria (a bacteriophage) accidentally transfers a piece of bacterial DNA, including a resistance gene, from one host bacterium to a new one it infects. [3]
This sharing accelerates the spread of resistance dramatically, creating "superbugs" much faster than simple reproduction allows. [3][7] Considering how rapidly some bacteria can divide—sometimes in under 20 minutes under ideal conditions—the speed at which these resistance genes can propagate through a localized population, especially in high-density environments like hospitals or livestock settings, means that widespread resistance can emerge surprisingly quickly once a resistance mechanism is present. [7]
# Countering Drugs

Once a pathogen acquires a mechanism or a mutation that confers resistance, it employs specific biochemical strategies to defeat the drug. [3][7] These strategies target the way the drug is supposed to work. For instance, if an antibiotic is designed to break down the bacterial cell wall, the resistant bacteria might stop making that structure correctly or change the target site entirely. [3]
The ways pathogens bypass antimicrobial action generally fall into a few key categories:
- Drug Inactivation: The microbe produces an enzyme that chemically breaks down or modifies the drug, rendering it useless before it can reach its target. A classic example is the production of beta-lactamase enzymes that destroy penicillin-type antibiotics. [3][7]
- Target Site Modification: The drug usually binds to a specific target within the pathogen (like a ribosome or an enzyme) to halt its processes. The pathogen mutates that binding site so the drug can no longer attach effectively. [3][7]
- Efflux Pumps: Bacteria can develop specialized protein pumps embedded in their membranes. These pumps actively recognize the antimicrobial agent and push it out of the cell as fast as it enters, keeping the internal drug concentration too low to be effective. [3][7]
- Metabolic Bypass: If the drug works by blocking a necessary metabolic pathway, the pathogen may evolve an alternative biochemical pathway to produce the essential substance it needs, effectively ignoring the drug's blockade. [3]
# Selection Pressure
While genetics provides the means for resistance, human behavior provides the motive or the pressure that makes resistance common in a population. [8] The development of resistance is a clear demonstration of Darwinian natural selection in action. [7][8]
When an antimicrobial drug is used, it kills the vast majority of susceptible pathogens causing an infection. However, if any pathogens in that population possess a resistance trait—either through mutation or gene transfer—they survive the treatment. [7] These survivors are now the only ones left to multiply, and since they are resistant, their offspring will also be resistant. [8] This process, known as selection pressure, means that the more we use an antimicrobial, the stronger the selective environment becomes for resistant strains to dominate. [1][8]
The major drivers for this selection pressure come from the overuse and misuse of antimicrobials across human health, animal agriculture, and even in the environment. [1][8][9]
# Human Use
In human medicine, resistance blooms when antibiotics are prescribed unnecessarily—for instance, to treat viral infections like the common cold or the flu, against which antibiotics are completely useless. [1][4] Furthermore, when a patient stops taking a prescribed course of antibiotics early because they feel better, they might not have killed off the hardiest, slightly more resistant bacteria, allowing those tenacious few to multiply and cause a relapse with a more difficult-to-treat infection. [1][4] In addition to patient misuse, resistance is sometimes exacerbated when broad-spectrum antibiotics—those that kill a wide range of bacteria—are used when a narrow-spectrum drug would have sufficed, unnecessarily subjecting more environmental bacteria to the drug's effects. [8]
# Agriculture and Environment
The scale of antimicrobial use in food-producing animals is substantial, often involving the routine use of these drugs for growth promotion or disease prevention in crowded herds, rather than just treating active illness. [8] While this practice is being curtailed in some regions, where it remains common, it contributes significantly to the reservoir of resistant bacteria in animals, which can then transfer to humans through the food chain or direct contact. [8]
A less frequently discussed, but critical, pathway is the environmental contamination from manufacturing waste, improper disposal of unused medications, and untreated sewage. [9] When low concentrations of antimicrobials enter soil and water systems, they create a vast, low-level selection pressure in environmental bacteria, serving as a massive mixing vessel where resistance genes can evolve and jump between different microbial species before potentially re-entering human or animal populations. [9] It's a sobering thought that the water runoff from an agricultural area or a poorly managed pharmaceutical waste site can act as a slow-motion incubator for future global health threats. [9]
# Pathways of Spread
Understanding how resistance develops genetically is one thing; understanding how it spreads globally is another, and this often involves movement between settings. [8] The issue isn't just about the individual pathogen in an infected person; it’s about the entire ecosystem of microbes.
The transfer of resistance genes from one organism to another, as mentioned earlier via horizontal gene transfer, is the primary driver of in-situ evolution. [3][7] However, the geographical spread of resistant organisms themselves relies on movement:
- Patient Movement: A person infected with a resistant organism in one country can travel across the globe, carrying that pathogen with them, effectively exporting the resistance problem. [8]
- Food Chain Contamination: As noted, resistant bacteria from livestock can contaminate meat or other food products that are then consumed or improperly handled, spreading the resistant strain to new hosts. [8]
- Global Trade: The international trade of food and animals means resistant microbes can cross borders rapidly, outpacing local public health measures. [8]
When we look at the global picture, the sheer volume of antimicrobial use—estimated to be hundreds of thousands of tons annually worldwide—creates a constant gradient favoring resistance development everywhere, not just in clinical settings. [6] This ubiquitous exposure means that even in remote locations with minimal pharmaceutical access, if resistant strains are introduced, they have the genetic potential to thrive. [9]
# Analyzing the Gap
The rate at which pathogens evolve resistance often seems to outpace our ability to discover and approve new drugs. This suggests an inherent biological advantage for the microbes in this evolutionary race. Drugs are designed to be highly specific toxins or inhibitors, meaning the resistance mechanism only needs to slightly alter the binding site or create one simple enzyme to negate the drug's entire function. [3] Conversely, developing a new antibiotic requires a compound that can navigate the body's defenses, reach the pathogen at a high enough concentration, and possess a novel mechanism that the pathogen has not yet adapted to defeat—a much more complex and expensive feat. [7] For a drug to be considered viable, it must overcome years of trials, and the evolutionary clock is ticking even while the drug is in development. This real-world scenario underscores why rigorous stewardship—saving our existing arsenal—is currently a more immediate and effective strategy than relying solely on the future pipeline of new medications. [1][4]
# Actionable Stewardship
Because the problem is so deeply rooted in how we use these critical medicines, effective intervention must be multi-pronged and focused on reducing selection pressure at every level. Beyond the standard advice to finish prescriptions, individuals can take proactive steps to limit their contribution to the pool of resistance. One practical measure is to be highly skeptical of any prescription for an antimicrobial when you have a viral illness, such as a cold or the flu; asking your healthcare provider if the treatment is truly necessary for a bacterial infection is a crucial first step in personal stewardship. [1] Furthermore, ensuring that livestock products consumed are sourced from farms adhering to strict antimicrobial management guidelines, when possible, helps reduce an indirect route of exposure. [8] This proactive filtering of choices, from the pharmacy to the grocery store, transforms passive patienthood into active co-management of global health resources.
The development of drug resistance is a natural biological process amplified by human behavior. [7][8] It is a continuous, dynamic process driven by evolution and accelerated by widespread use. [1][3] Stopping the clock on this development is impossible, but slowing it down through careful, deliberate antimicrobial stewardship remains our most powerful defense against entering a post-antibiotic era where routine infections become medical disasters. [4][6]
#Videos
Mechanisms of antibiotic resistance - YouTube
Related Questions
#Citations
What is Antibiotic Resistance
About Antimicrobial Resistance - CDC
How Bacteria Build Resistance at the Cellular Level
Antibiotic Resistance: What Is It, Complications & Treatment
Mechanisms of antibiotic resistance - YouTube
Antimicrobial resistance - World Health Organization (WHO)
How do bacteria actually become resistant to antibiotics?
What causes AMR? - Antimicrobial resistance
An overview of the antimicrobial resistance mechanisms of bacteria


